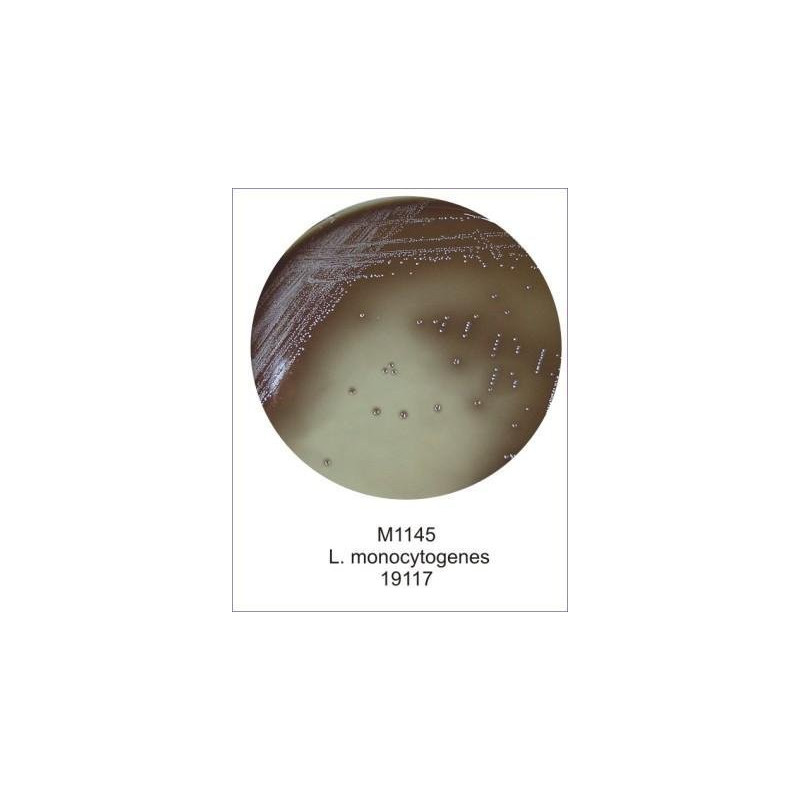

FD126 Listeria Moxalatum Supplement / Моксалактамова добавка для лістерій.
Рекомендується для селективного виділення Listeria monocytogenes зі змішаних культур.
Склад:
(Одного флакона достатньо для 500 мл середовища)
Моксалактам - 7,5 мг
Колістіна сульфат - 5,0 мг
Доставка
Умови повернення та обміну
Вказівки щодо застосування:
Асептично розчинити в 2 мл дистильованої стерильної води, уникаючи піноутворення, і додати до 500 мл стерильної розплавленої основи Оксфордського середовища для лістерій (M1145). Ретельно перемішати та розлити середовище у стерильні чашки Петрі.